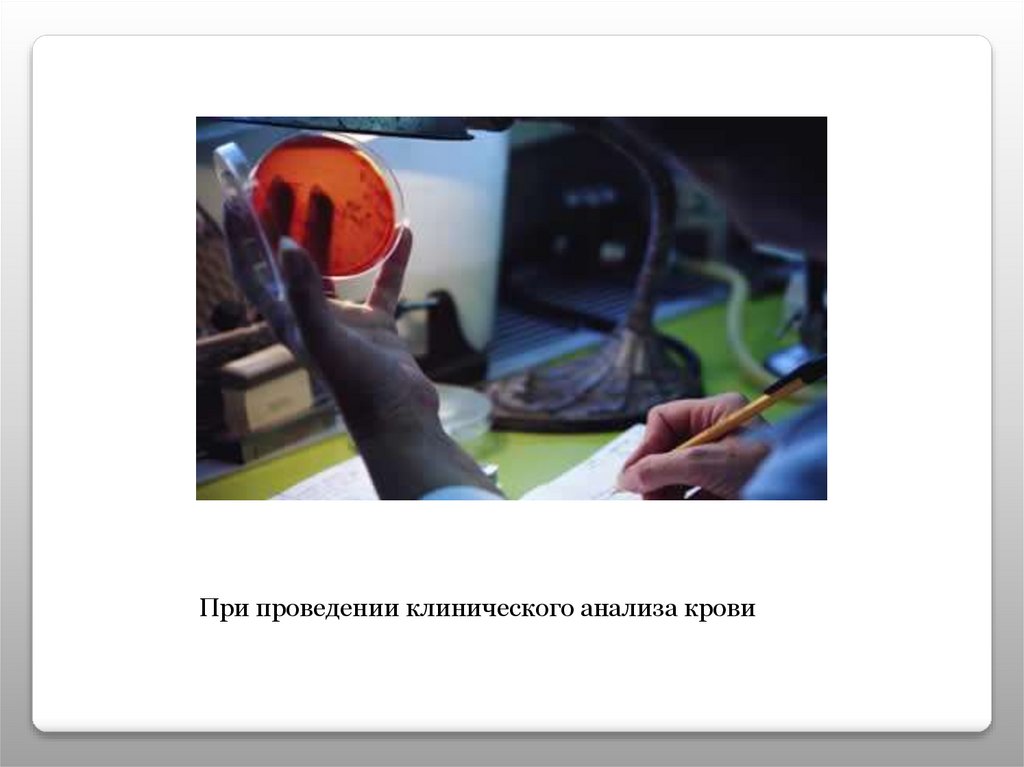

Similar presentations:
cb68d8bcd19e4a87b778f4779d5c921b
1. Предельные одноатомные спирты
2.
Спирты – это производныеуглеводородов, где один или несколько
водородных атомов замещены на
гидроксогруппу.
3. Гомологический ряд спиртов
Молекулярнаяформула
Полуструктурная формула
Название спирта
СН3ОН
СН3-ОН
Метанол
С2Н5ОН
СН3-СН2-ОН
Этанол
С3Н7ОН
СН3-СН2-СН2-ОН
Пропанол
С4Н9ОН
СН3-СН2-СН2-СН2-ОН
Бутанол
С5Н11ОН
СН3-СН2-СН2-СН2-СН2-ОН
Пентанол
4. Функциональная группа спиртов
При смещении электронной плотности от водородак кислороду, возможна некоторая подвижность
атома водорода, что приводит к появлению слабых
кислотных свойств.
5. Водородная связь
Уменьшение расстояния между молекулами спиртовприводит к тому, что среди спиртов нет газообразных
Веществ, но температура кипения их низкая.
6. Классификация спиртов
7.
Одноатомныеспирты
СН3-СН2-СН2-ОН
пропанол -1
Двухатомные
спирты
Трехатомные
спирты
СН2-СН-СН3
l
l
ОН ОН
Этиленгликоль
СН2-СН-СН2
l
l
l
ОН ОН ОН
глицерин
8. Номенклатура спиртов
Систематические названия даются по названию углеводорода сдобавлением суффикса -ол и цифры, указывающей положение
гидроксигруппы (если это необходимо). Например:
Нумерация ведется от ближайшего к ОН-группе конца цепи.
9. Изомерия спиртов
1. Для спиртов характерна структурная изомерия:изомерия положения ОН-группы (начиная с С3)
2. углеродного скелета (начиная с С4)
3. межклассовая изомерия с простыми эфирами
СН3-CH2–OH и CH3–O–CH3
10. Химические свойства спиртов
1. Взаимодействие с галогеноводородами, подобнощелочей с кислотами
2. Дегидратация.
А) внутримолекулярная
взаимодействию
11.
Б) межмолекулярная3. Горение
С2Н5ОН + 3 О2 →
2 СО2 + 3 Н2О
С3Н7ОН + 4,5 О2 → 3 СО2 + 4 Н2О
С3Н7ОН + 9 О2 → 6 СО2 + 8 Н2О
12.
4. Спирты взаимодействуют со щелочными ищелочно-земельными металлами
2СН3-СН2-ОН + 2К → 2СН3-СН2-ОК + Н2
2СН3-СН2-ОН + Са → (СН3-СН2-О)2Са + Н2
13. Способы получение спиртов
Лабораторные:Гидролиз галогеналканов
Гидратация этиленовых углеводородов
образуется вторичный спирт по правилу Марковникова
14.
Гидрирование карбонильных соединений15.
Промышленные:Получение метанола из синтез-газа
16. Применение спиртов
Получение лекарств17.
Обеззараживание18.
Производство лаков и красок19.
При проведении клинического анализа крови20.
В качестве автомобильного топлива21.
Как добавка к реактивному топливу22.
В качестве растворителя23.
Сырье для получения каучука24.
Сырье для производства уксусной кислоты25. Проверь себя
1. Общая формула предельныходноатомных спиртов
а) CnH2n+2
б) CnH2n
в) CnH2n-2
г) CnH2n+1OH
26.
2. Функциональная группапредельных одноатомных спиртов
а) - СНО
б) - СООН
в) - ОН
г) - СН3
27.
3. Реакции по разрыву связив гидроксогруппе
а) с галогенами;
б) с кислородом;
в) с активными металлами;
г) с оксидом меди (ІІ);
28.
Реакция с отрывомгидроксогруппы
а) окисление;
б) гидрирование;
в) гидратация;
г) дегидратация (+)

chemistry
chemistry








